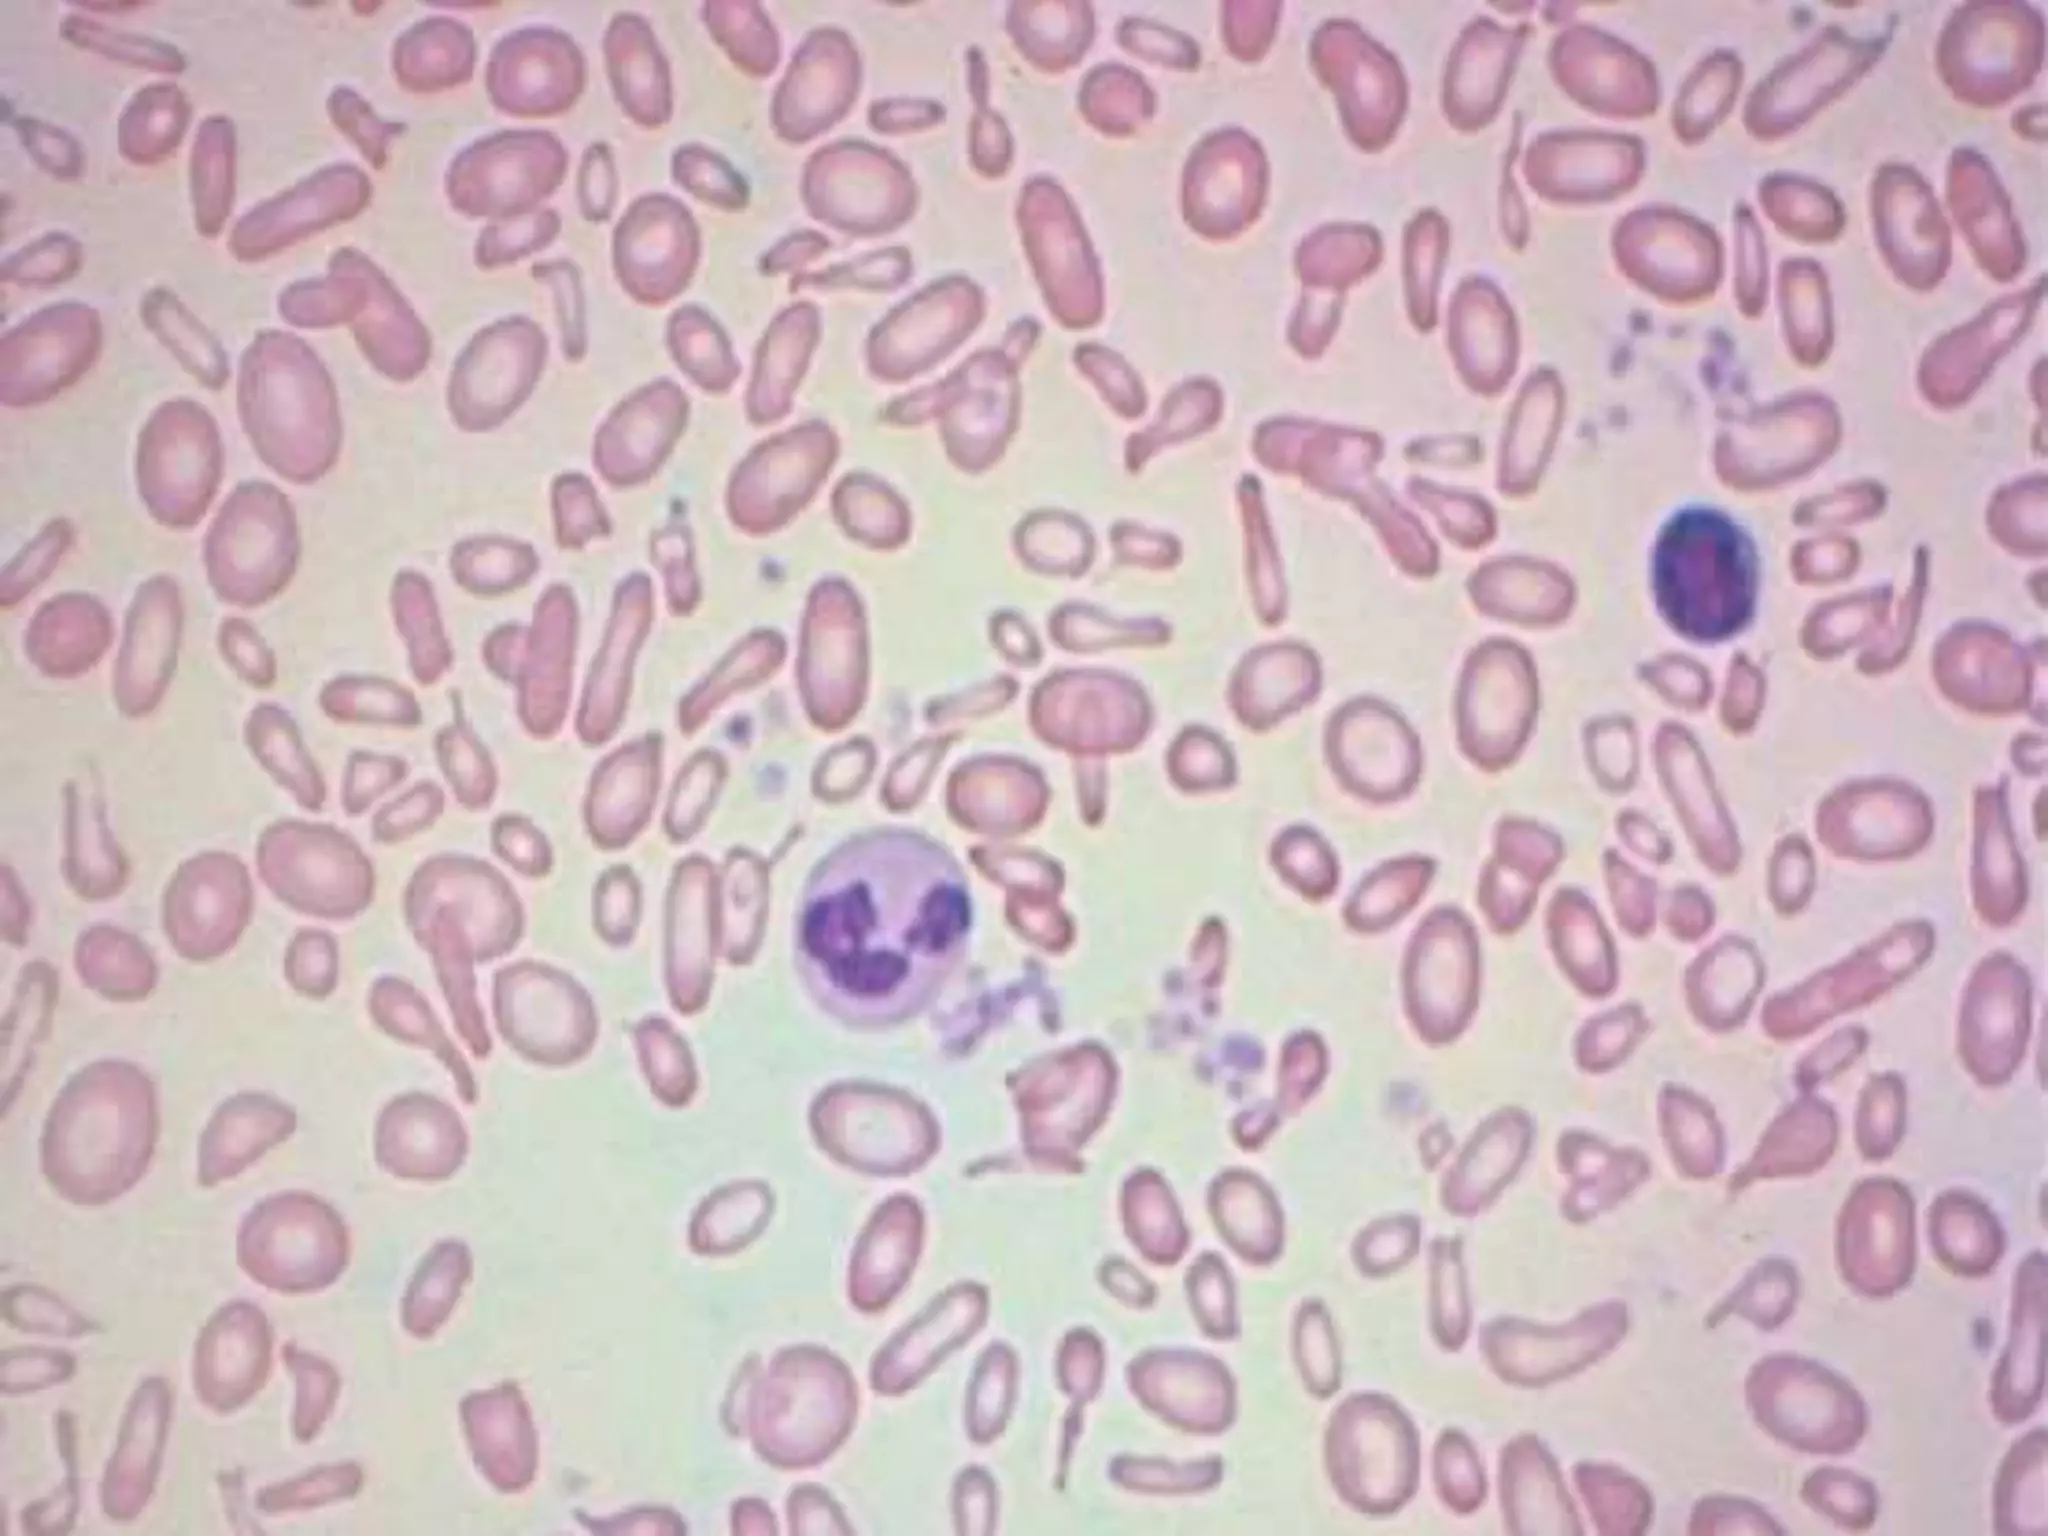
PS Findings In Hemolytic Anemia.pptx
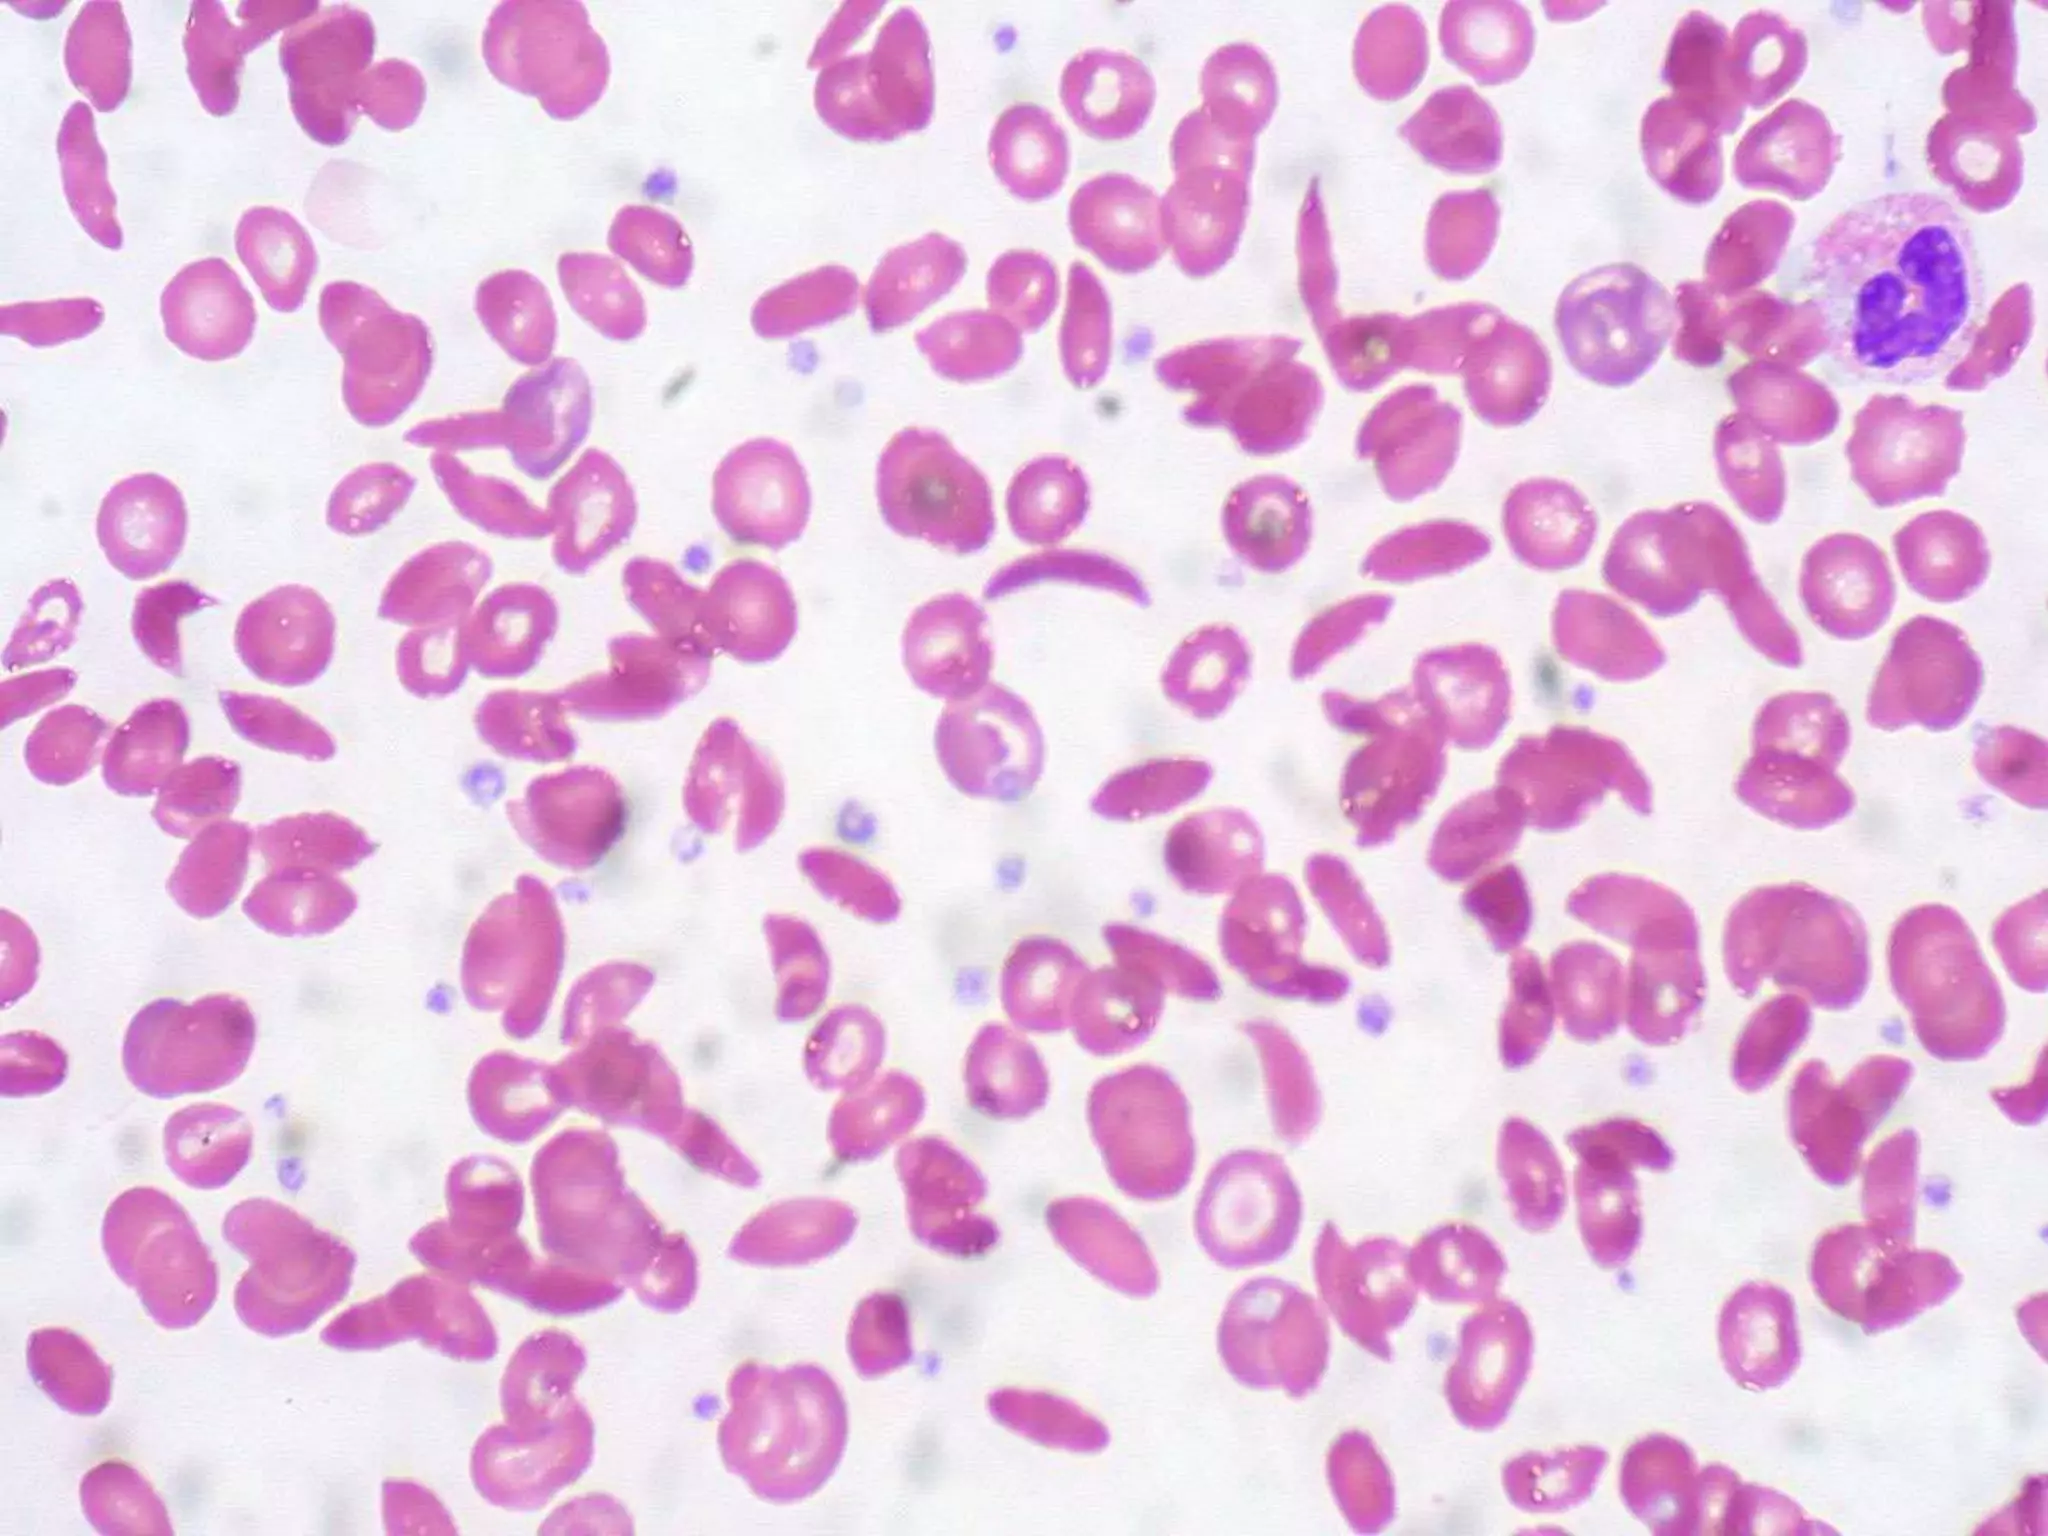
PS Findings In Hemolytic Anemia.pptx

Embed presentation



































Hemolytic anemia is a condition where red blood cells are destroyed and removed from circulation faster than they can be replaced. The patient's medical record shows findings related to hemolytic anemia including signs and symptoms of anemia like fatigue, jaundice, and abdominal pain as well as lab results showing low hemoglobin and elevated bilirubin. Further tests are needed to determine the underlying cause of hemolysis in this patient.